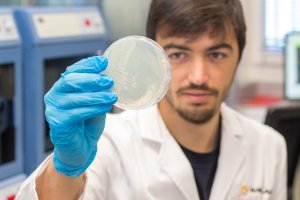

Mabeconta presenta contadores de agua que garantizan la precisión en la medida
Mabeconta empresa española especializada en medición de caudal, filtración de líquidos y dosificación, con más de 40 años de experiencia en el sector, cuenta ...

Mabeconta empresa española especializada en medición de caudal, filtración de líquidos y dosificación, con más de 40 años de experiencia en el sector, cuenta ...

Sato, líder mundial en soluciones de etiquetado y auto-ID, ha anunciado el lanzamiento de su nueva impresora CL6NX Plus, una solución de impresión térmica inmejorable diseñada ...

Quadpack, fabricante y proveedor internacional de packaging para el sector de la belleza, ha aplicado su experiencia con la madera para aumentar su funcionalidad. Woodacity® es una nueva gama de sistemas ...

Una gama completa y renovada de papeles térmicos especialmente diseñados para evolucionar con su negocio. Gracias a sus amplios conocimientos tecnológicos y a su larga experiencia ...
Los proyectos BIONPLA, CAPMAM y EFFICIENTHEATING alineados con la economía circular y la descarbonización de la economía, permitirán al tejido industrial valenciano poner en ...

SICK, proveedor de soluciones basadas en sensores, lanza LBR SicWave y LFR SicWave. Estos dos nuevos sensores completan la gama actual de productos de la firma y revolucionan la medición de nivel ...

i3D ecopackaging ideas, empresa barcelonesa especializada en packaging sostenible, sigue su plan de expansión y hace pocos meses que ha lanzado al mercado una nueva gama de productos reutilizables ...

Domino Printing Sciences (Domino) tiene el placer de anunciar el lanzamiento de la nueva K600G, una innovadora solución de impresión digital sobre bobinas y láminas de blíster ...

En las diferentes etapas de fabricación de bienes de consumo, como en la industria alimentaria, la industria farmacéutica o incluso la cosmética, es imprescindible medir con precisión ...

Hinojosa, líder en soluciones globales de envasado en la Península Ibérica, lanza ECOGRIP, una alternativa de cartón ondulado a la envoltura de plástico utilizada para ...

El fabricante español líder de equipos de conversión, Enprom Solutions, ha lanzado recientemente su última innovación, la eRR40, una inspeccionadora y rebobinadora dual ...

Los productores industriales ahora pueden mejorar la confiabilidad y duración de sus sistemas de automatización en localizaciones peligrosas. Rockwell Automation ha mejorado dos de sus modernas ...

La gama Tintoretto para el etiquetado de marcas de alta gama de la colección Manter se amplía con la introducción del color marfil con tratamiento H+Opacity™. La gama Tintoretto ...

Smurfit Kappa, líder del sector de embalaje de papel y cartón ondulado, se ha unido a KHS ─uno de los principales fabricantes del mundo de sistemas de llenado y envasado para la industria ...















